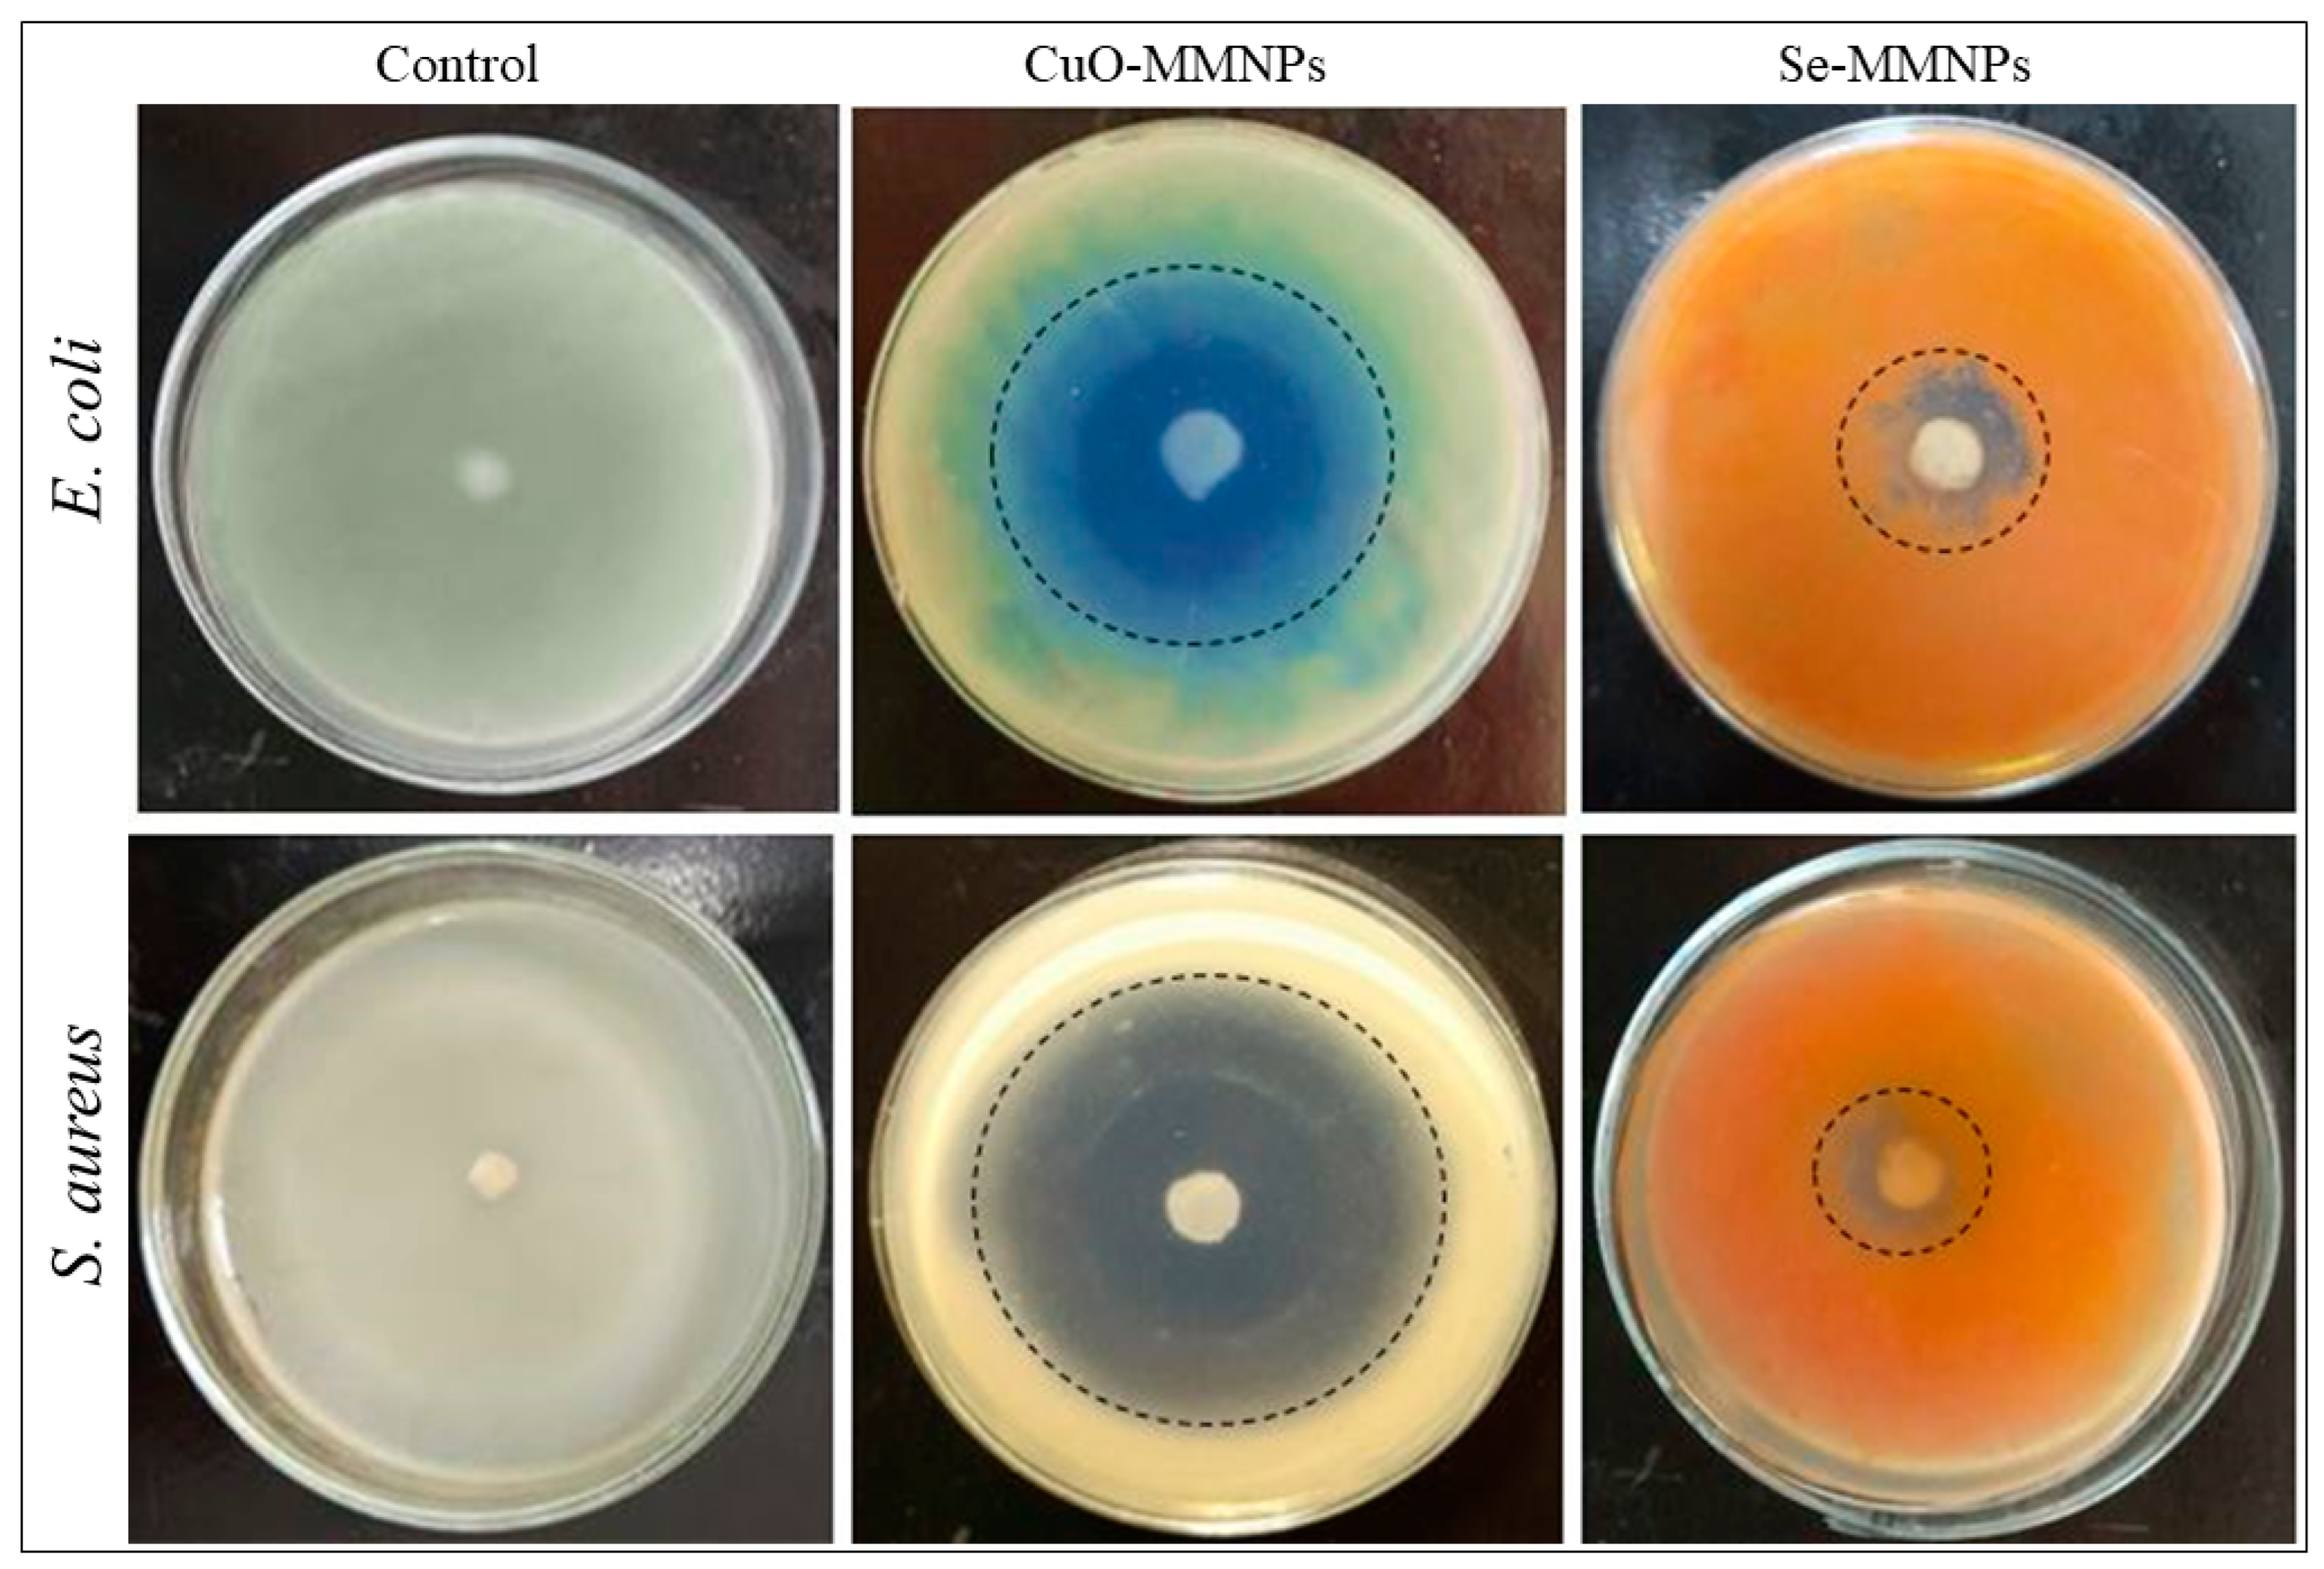
Biomedicines 12 00994 g003

Biogenic Synthesis of Selenium and Copper Oxide Nanoparticles and Inhibitory Effect against Multi-Drug Resistant Biofilm-Forming Bacterial Pathogens
Abstract
1. Introduction
2. Materials and Methods
2.1. Chemicals and Reagents
2.2. Synthesis of Monometallic Nanoparticles
2.3. Physiochemical Characterization of Se and CuO Monometallic Nanoparticles
2.4. Antibacterial Activity
2.5. Determination of Minimum Inhibitory Concentration (MIC)
2.6. Killing Kinetics Study
2.7. Inhibition of Biofilm Formation
2.8. Statistical Analysis
3. Results and Discussion
3.1. Biogenic Synthesis of Se-MMNPs and CuO-Monometallic Nanoparticles
3.2. Characterization of Synthesized Monometallic Nanoparticles
3.3. Qualitative Antimicrobial Assays
3.4. Time–Kill Kinetics Assay
3.5. Quantitative Detection of Biofilm Formation
3.6. Antibacterial Mechanism: Action of Nanomaterials and Unveiling the Battle against Bacterial Infections
4. Conclusions
Author Contributions
Funding
Institutional Review Board Statement
Informed Consent Statement
Data Availability Statement
Conflicts of Interest
References
- Wang, D.; Xue, B.; Wang, L.; Zhang, Y.; Liu, L.; Zhou, Y. Fungus-mediated green synthesis of nano-silver using Aspergillus sydowii and its antifungal/antiproliferative activities. Sci. Rep. 2021, 11, 10356. [Google Scholar] [CrossRef]
- Mohanpuria, P.; Rana, N.K.; Yadav, S.K. Biosynthesis of nanoparticles: Technological concepts and future applications. J. Nanopart. Res. 2008, 10, 507–517. [Google Scholar] [CrossRef]
- Liu, J.; Qiao, S.Z.; Hu, Q.H.; Lu, G.Q. Magnetic Nanocomposites with Mesoporous Structures: Synthesis and Applications. Small 2011, 7, 425–443. [Google Scholar] [CrossRef] [PubMed]
- Dobrucka, R. Biogenic synthesis of trimetallic nanoparticles Au/ZnO/Ag using Meliloti officinalis extract. Int. J. Environ. Anal. Chem. 2020, 100, 981–991. [Google Scholar] [CrossRef]
- Raghunath, A.; Perumal, E. Metal oxide nanoparticles as antimicrobial agents: A promise for the future. Int. J. Antimicrob. Agents 2017, 49, 137–152. [Google Scholar] [CrossRef]
- Dhingra, S.; Rahman, N.A.A.; Peile, E.; Rahman, M.; Sartelli, M.; Hassali, M.A.; Islam, T.; Islam, S.; Haque, M. Microbial Resistance Movements: An Overview of Global Public Health Threats Posed by Antimicrobial Resistance, and How Best to Counter. Front. Public Health 2020, 8, 535668. [Google Scholar] [CrossRef] [PubMed]
- Murray, C.J.L.; Ikuta, K.S.; Sharara, F.; Swetschinski, L.; Robles Aguilar, G.; Gray, A.; Han, C.; Bisignano, C.; Rao, P.; Wool, E.; et al. Global burden of bacterial antimicrobial resistance in 2019: A systematic analysis. Lancet 2022, 399, 629–655. [Google Scholar] [CrossRef] [PubMed]
- Helmy, Y.A.; Taha-Abdelaziz, K.; Hawwas, H.A.E.-H.; Ghosh, S.; AlKafaas, S.S.; Moawad, M.M.M.; Saied, E.M.; Kassem, I.I.; Mawad, A.M.M. Antimicrobial Resistance and Recent Alternatives to Antibiotics for the Control of Bacterial Pathogens with an Emphasis on Foodborne Pathogens. Antibiotics 2023, 12, 274. [Google Scholar] [CrossRef]
- Aboelenin, A.M.; El-Mowafy, M.; Saleh, N.M.; Shaaban, M.I.; Barwa, R. Ciprofloxacin- and levofloxacin-loaded nanoparticles efficiently suppressed fluoroquinolone resistance and biofilm formation in Acinetobacter baumannii. Sci. Rep. 2024, 14, 3125. [Google Scholar] [CrossRef]
- Medina, E.; Pieper, D.H. Tackling Threats and Future Problems of Multidrug-Resistant Bacteria. In How to Overcome the Antibiotic Crisis: Facts, Challenges, Technologies and Future Perspectives; Springer: Berlin/Heidelberg, Germany, 2016; pp. 3–33. [Google Scholar] [CrossRef]
- Vimbela, G.V.; Ngo, S.M.; Fraze, C.; Yang, L.; Stout, D.A. Antibacterial properties and toxicity from metallic nanomaterials. Int. J. Nanomed. 2017, 12, 3941–3965. [Google Scholar] [CrossRef]
- Padilla-Cruz, A.L.; Garza-Cervantes, J.A.; Vasto-Anzaldo, X.G.; García-Rivas, G.; León-Buitimea, A.; Morones-Ramírez, J.R. Synthesis and design of Ag–Fe bimetallic nanoparticles as antimicrobial synergistic combination therapies against clinically relevant pathogens. Sci. Rep. 2021, 11, 5351. [Google Scholar] [CrossRef] [PubMed]
- Rehman, F.; Deshmukh, S.; Ingle, A.; Gade, A.; Rai, M. Silver Nanoparticles: Novel Antimicrobial Agent Synthesized from an Endophytic Fungus Pestalotia sp. Isolated from Leaves of Syzygium cumini (L). Nano Biomed. Eng. 2011, 3, 174–178. [Google Scholar] [CrossRef]
- Singh, P.; Garg, A.; Pandit, S.; Mokkapati, V.R.S.S.; Mijakovic, I. Antimicrobial Effects of Biogenic Nanoparticles. Nanomaterials 2018, 8, 1009. [Google Scholar] [CrossRef] [PubMed]
- Natan, M.; Banin, E. From Nano to Micro: Using nanotechnology to combat microorganisms and their multidrug resistance. FEMS Microbiol. Rev. 2017, 41, 302–322. [Google Scholar] [CrossRef] [PubMed]
- Tian, X.; Jiang, X.; Welch, C.; Croley, T.R.; Wong, T.-Y.; Chen, C.; Fan, S.; Chong, Y.; Li, R.; Ge, C.; et al. Bactericidal Effects of Silver Nanoparticles on Lactobacilli and the Underlying Mechanism. ACS Appl. Mater. Interfaces 2018, 10, 8443–8450. [Google Scholar] [CrossRef] [PubMed]
- Didem Şen, K.; Suvi, M.; Adyary, F.; Jessica, M.R. Current Approaches for Exploration of Nanoparticles as Antibacterial Agents. In Antibacterial Agents; IntechOpen Limited: London, UK, 2017; Chapter 4. [Google Scholar] [CrossRef]
- Brar, B.; Marwaha, S.; Poonia, A.K.; Koul, B.; Kajla, S.; Rajput, V.D. Nanotechnology: A contemporary therapeutic approach in combating infections from multidrug-resistant bacteria. Arch. Microbiol. 2023, 205, 62. [Google Scholar] [CrossRef] [PubMed]
- Yeh, Y.-C.; Huang, T.-H.; Yang, S.-C.; Chen, C.-C.; Fang, J.-Y. Nano-Based Drug Delivery or Targeting to Eradicate Bacteria for Infection Mitigation: A Review of Recent Advances. Front. Chem. 2020, 8, 286. [Google Scholar] [CrossRef] [PubMed]
- Baptista, P.V.; McCusker, M.P.; Carvalho, A.; Ferreira, D.A.; Mohan, N.M.; Martins, M.; Fernandes, A.R. Nano-Strategies to Fight Multidrug Resistant Bacteria—“A Battle of the Titans”. Front. Microbiol. 2018, 9, 1441. [Google Scholar] [CrossRef] [PubMed]
- Souza, L.M.d.S.; Dibo, M.; Sarmiento, J.J.P.; Seabra, A.B.; Medeiros, L.P.; Lourenço, I.M.; Kobayashi, R.K.T.; Nakazato, G. Biosynthesis of selenium nanoparticles using combinations of plant extracts and their antibacterial activity. Curr. Res. Green Sustain. Chem. 2022, 5, 100303. [Google Scholar] [CrossRef]
- Amer, M.; Awwad, A. Green synthesis of copper nanoparticles by Citrus limon fruits extract, characterization and antibacterial activity. Chem. Int. 2020, 7, 1–8. [Google Scholar] [CrossRef]
- Mohamed, A.A.; Abu-Elghait, M.; Ahmed, N.E.; Salem, S.S. Eco-friendly Mycogenic Synthesis of ZnO and CuO Nanoparticles for In Vitro Antibacterial, Antibiofilm, and Antifungal Applications. Biol. Trace Elem. Res. 2021, 199, 2788–2799. [Google Scholar] [CrossRef]
- Zangeneh, M.M.; Ghaneialvar, H.; Akbaribazm, M.; Ghanimatdan, M.; Abbasi, N.; Goorani, S.; Pirabbasi, E.; Zangeneh, A. Novel synthesis of Falcaria vulgaris leaf extract conjugated copper nanoparticles with potent cytotoxicity, antioxidant, antifungal, antibacterial, and cutaneous wound healing activities under in vitro and in vivo condition. J. Photochem. Photobiol. B Biol. 2019, 197, 111556. [Google Scholar] [CrossRef] [PubMed]
- Adibian, F.; Ghaderi, R.S.; Sabouri, Z.; Davoodi, J.; Kazemi, M.; Ghazvini, K.; Youssefi, M.; Soleimanpour, S.; Darroudi, M. Green synthesis of selenium nanoparticles using Rosmarinus officinalis and investigated their antimicrobial activity. BioMetals 2022, 35, 147–158. [Google Scholar] [CrossRef]
- Ghaderi, R.S.; Adibian, F.; Sabouri, Z.; Davoodi, J.; Kazemi, M.; Amel Jamehdar, S.; Meshkat, Z.; Soleimanpour, S.; Daroudi, M. Green synthesis of selenium nanoparticle by Abelmoschus esculentus extract and assessment of its antibacterial activity. Mater. Technol. 2022, 37, 1289–1297. [Google Scholar] [CrossRef]
- Makarov, V.; Love, A.; Sinitsyna, O.; Makarova, S.; Yaminsky, I.; Taliansky, M.; Kalinina, N. “Green” nanotechnologies: Synthesis of metal nanoparticles using plants. Acta Nat. 2014, 6, 35–44. [Google Scholar] [CrossRef]
- Iravani, S. Green synthesis of metal nanoparticles using plants. Green Chem. 2011, 13, 2638–2650. [Google Scholar] [CrossRef]
- Consolo, V.F.; Torres-Nicolini, A.; Alvarez, V.A. Mycosinthetized Ag, CuO and ZnO nanoparticles from a promising Trichoderma harzianum strain and their antifungal potential against important phytopathogens. Sci. Rep. 2020, 10, 20499. [Google Scholar] [CrossRef]
- Gopinath, K.; Karthika, V.; Sundaravadivelan, C.; Gowri, S.; Arumugam, A. Mycogenesis of cerium oxide nanoparticles using Aspergillus niger culture filtrate and their applications for antibacterial and larvicidal activities. J. Nanostruct. Chem. 2015, 5, 295–303. [Google Scholar] [CrossRef]
- Kalyani, P.; Lakshmi, B.; Dinesh, R.; Hemalatha, K. Green synthesis of silver nanoparticles by using aspergillus fumigatus and their antibacterial activity. Int. J. Curr. Res. Life Sci. 2018, 7, 788–791. [Google Scholar]
- Fouda, A.; Abdel-Maksoud, G.; Abdel-Rahman, M.A.; Salem, S.S.; Hassan, S.E.-D.; El-Sadany, M.A.-H. Eco-friendly approach utilizing green synthesized nanoparticles for paper conservation against microbes involved in biodeterioration of archaeological manuscript. Int. Biodeterior. Biodegrad. 2019, 142, 160–169. [Google Scholar] [CrossRef]
- Abd El Aty, A.A.; Mohamed, A.A.; Zohair, M.M.; Soliman, A.A.F. Statistically controlled biogenesis of silver nano-size by Penicillium chrysogenum MF318506 for biomedical application. Biocatal. Agric. Biotechnol. 2020, 25, 101592. [Google Scholar] [CrossRef]
- Vinale, F.; Nicoletti, R.; Lacatena, F.; Marra, R.; Sacco, A.; Lombardi, N.; d’Errico, G.; Digilio, M.C.; Lorito, M.; Woo, S.L. Secondary metabolites from the endophytic fungus Talaromyces pinophilus. Nat. Prod. Res. 2017, 31, 1778–1785. [Google Scholar] [CrossRef] [PubMed]
- Sun, B.-D.; Chen, A.J.; Houbraken, J.; Frisvad, J.C.; Wu, W.-P.; Wei, H.-L.; Zhou, Y.-G.; Jiang, X.-Z.; Samson, R.A. New section and species in Talaromyces. MycoKeys 2020, 68, 75. [Google Scholar] [CrossRef] [PubMed]
- Abbas, S.; Uzair, B.; Sajjad, S.; Leghari, S.A.K.; Noor, S.; Niazi, M.B.K.; Farooq, I.; Iqbal, H. Dual-Functional Green Facile CuO/MgO Nanosheets Composite as an Efficient Antimicrobial Agent and Photocatalyst. Arab. J. Sci. Eng. 2022, 47, 5895–5909. [Google Scholar] [CrossRef]
- Khane, Y.; Benouis, K.; Albukhaty, S.; Sulaiman, G.M.; Abomughaid, M.M.; Al Ali, A.; Aouf, D.; Fenniche, F.; Khane, S.; Chaibi, W.; et al. Green Synthesis of Silver Nanoparticles Using Aqueous Citrus limon Zest Extract: Characterization and Evaluation of Their Antioxidant and Antimicrobial Properties. Nanomaterials 2022, 12, 2013. [Google Scholar] [CrossRef] [PubMed]
- Alahmad, A.; Al-Zereini, W.A.; Hijazin, T.J.; Al-Madanat, O.Y.; Alghoraibi, I.; Al-Qaralleh, O.; Al-Qaraleh, S.; Feldhoff, A.; Walter, J.-G.; Scheper, T. Green Synthesis of Silver Nanoparticles Using Hypericum perforatum L. Aqueous Extract with the Evaluation of Its Antibacterial Activity against Clinical and Food Pathogens. Pharmaceutics 2022, 14, 1104. [Google Scholar] [CrossRef] [PubMed]
- Mourdikoudis, S.; Pallares, R.M.; Thanh, N.T.K. Characterization techniques for nanoparticles: Comparison and complementarity upon studying nanoparticle properties. Nanoscale 2018, 10, 12871–12934. [Google Scholar] [CrossRef] [PubMed]
- Patiño-Ruiz, D.; Sánchez-Botero, L.; Tejeda-Benitez, L.; Hinestroza, J.; Herrera, A. Green synthesis of iron oxide nanoparticles using Cymbopogon citratus extract and sodium carbonate salt: Nanotoxicological considerations for potential environmental applications. Environ. Nanotechnol. Monit. Manag. 2020, 14, 100377. [Google Scholar] [CrossRef]
- Tamil Elakkiya, V.; Meenakshi, R.V.; Senthil Kumar, P.; Karthik, V.; Ravi Shankar, K.; Sureshkumar, P.; Hanan, A. Green synthesis of copper nanoparticles using Sesbania aculeata to enhance the plant growth and antimicrobial activities. Int. J. Environ. Sci. Technol. 2022, 19, 1313–1322. [Google Scholar] [CrossRef]
- Keskin, M.; Kaya, G.; Bayram, S.; Kurek-Górecka, A.; Olczyk, P. Green Synthesis, Characterization, Antioxidant, Antibacterial and Enzyme Inhibition Effects of Chestnut (Castanea sativa) Honey-Mediated Silver Nanoparticles. Molecules 2023, 28, 2762. [Google Scholar] [CrossRef]
- Shehabeldine, A.M.; Amin, B.H.; Hagras, F.A.; Ramadan, A.A.; Kamel, M.R.; Ahmed, M.A.; Atia, K.H.; Salem, S.S. Potential Antimicrobial and Antibiofilm Properties of Copper Oxide Nanoparticles: Time-Kill Kinetic Essay and Ultrastructure of Pathogenic Bacterial Cells. Appl. Biochem. Biotechnol. 2023, 195, 467–485. [Google Scholar] [CrossRef] [PubMed]
- Soliman, M.K.Y.; Salem, S.S.; Abu-Elghait, M.; Azab, M.S. Biosynthesis of Silver and Gold Nanoparticles and Their Efficacy Towards Antibacterial, Antibiofilm, Cytotoxicity, and Antioxidant Activities. Appl. Biochem. Biotechnol. 2023, 195, 1158–1183. [Google Scholar] [CrossRef] [PubMed]
- Pyrzynska, K.; Sentkowska, A. Biosynthesis of selenium nanoparticles using plant extracts. J. Nanostruct. Chem. 2022, 12, 467–480. [Google Scholar] [CrossRef]
- Ssekatawa, K.; Byarugaba, D.K.; Angwe, M.K.; Wampande, E.M.; Ejobi, F.; Nxumalo, E.; Maaza, M.; Sackey, J.; Kirabira, J.B. Phyto-Mediated Copper Oxide Nanoparticles for Antibacterial, Antioxidant and Photocatalytic Performances. Front. Bioeng. Biotechnol. 2022, 10, 820218. [Google Scholar] [CrossRef] [PubMed]
- Sarkar, R.D.; Lahkar, P.; Kalita, M.C. Glycosmis pentaphylla (Retz.) DC leaf extract mediated synthesis of selenium nanoparticle and investigation of its antibacterial activity against urinary tract pathogens. Bioresour. Technol. Rep. 2022, 17, 100894. [Google Scholar] [CrossRef]
- Mali, S.C.; Dhaka, A.; Githala, C.K.; Trivedi, R. Green synthesis of copper nanoparticles using Celastrus paniculatus Willd. leaf extract and their photocatalytic and antifungal properties. Biotechnol. Rep. 2020, 27, e00518. [Google Scholar] [CrossRef] [PubMed]
- Chandraker, S.K.; Lal, M.; Ghosh, M.K.; Tiwari, V.; Ghorai, T.K.; Shukla, R. Green synthesis of copper nanoparticles using leaf extract of Ageratum houstonianum Mill. and study of their photocatalytic and antibacterial activities. Nano Express 2020, 1, 010033. [Google Scholar] [CrossRef]
- Ramya, S.; Shanmugasundaram, T.; Balagurunathan, R. Biomedical potential of actinobacterially synthesized selenium nanoparticles with special reference to anti-biofilm, anti-oxidant, wound healing, cytotoxic and anti-viral activities. J. Trace Elem. Med. Biol. 2015, 32, 30–39. [Google Scholar] [CrossRef]
- Salem, S.S.; Badawy, M.S.E.M.; Al-Askar, A.A.; Arishi, A.A.; Elkady, F.M.; Hashem, A.H. Green Biosynthesis of Selenium Nanoparticles Using Orange Peel Waste: Characterization, Antibacterial and Antibiofilm Activities against Multidrug-Resistant Bacteria. Life 2022, 12, 893. [Google Scholar] [CrossRef]
- Wu, S.; Rajeshkumar, S.; Madasamy, M.; Mahendran, V. Green synthesis of copper nanoparticles using Cissus vitiginea and its antioxidant and antibacterial activity against urinary tract infection pathogens. Artif. Cells Nanomed. Biotechnol. 2020, 48, 1153–1158. [Google Scholar] [CrossRef]
- Krishnan, M.; Ranganathan, K.; Maadhu, P.; Thangavelu, P.; Kundan, S.; Arjunan, N. Leaf Extract of Dillenia indica as a Source of Selenium Nanoparticles with Larvicidal and Antimicrobial Potential toward Vector Mosquitoes and Pathogenic Microbes. Coatings 2020, 10, 626. [Google Scholar] [CrossRef]
- Hashem, A.H.; Salem, S.S. Green and ecofriendly biosynthesis of selenium nanoparticles using Urtica dioica (stinging nettle) leaf extract: Antimicrobial and anticancer activity. Biotechnol. J. 2022, 17, 2100432. [Google Scholar] [CrossRef] [PubMed]
- Gold, K.; Slay, B.; Knackstedt, M.; Gaharwar, A.K. Antimicrobial Activity of Metal and Metal-Oxide Based Nanoparticles. Adv. Ther. 2018, 1, 1700033. [Google Scholar] [CrossRef]
- Shende, S.; Ingle, A.P.; Gade, A.; Rai, M. Green synthesis of copper nanoparticles by Citrus medica Linn. (Idilimbu) juice and its antimicrobial activity. World J. Microbiol. Biotechnol. 2015, 31, 865–873. [Google Scholar] [CrossRef] [PubMed]
- Srivastava, N.; Mukhopadhyay, M. Green synthesis and structural characterization of selenium nanoparticles and assessment of their antimicrobial property. Bioprocess Biosyst. Eng. 2015, 38, 1723–1730. [Google Scholar] [CrossRef] [PubMed]
- Zain, N.M.; Stapley, A.G.F.; Shama, G. Green synthesis of silver and copper nanoparticles using ascorbic acid and chitosan for antimicrobial applications. Carbohydr. Polym. 2014, 112, 195–202. [Google Scholar] [CrossRef] [PubMed]
- Nieto-Maldonado, A.; Bustos-Guadarrama, S.; Espinoza-Gomez, H.; Flores-López, L.Z.; Ramirez-Acosta, K.; Alonso-Nuñez, G.; Cadena-Nava, R.D. Green synthesis of copper nanoparticles using different plant extracts and their antibacterial activity. J. Environ. Chem. Eng. 2022, 10, 107130. [Google Scholar] [CrossRef]
- Boonyanugomol, W.; Kraisriwattana, K.; Rukseree, K.; Boonsam, K.; Narachai, P. In vitro synergistic antibacterial activity of the essential oil from Zingiber cassumunar Roxb against extensively drug-resistant Acinetobacter baumannii strains. J. Infect. Public Health 2017, 10, 586–592. [Google Scholar] [CrossRef] [PubMed]
- Punniyakotti, P.; Panneerselvam, P.; Perumal, D.; Aruliah, R.; Angaiah, S. Anti-bacterial and anti-biofilm properties of green synthesized copper nanoparticles from Cardiospermum halicacabum leaf extract. Bioprocess Biosyst. Eng. 2020, 43, 1649–1657. [Google Scholar] [CrossRef]
- Munir, M.U.; Ahmed, A.; Usman, M.; Salman, S. Recent Advances in Nanotechnology-Aided Materials in Combating Microbial Resistance and Functioning as Antibiotics Substitutes. Int. J. Nanomed. 2020, 15, 7329–7358. [Google Scholar] [CrossRef]
- Basavegowda, N.; Baek, K.-H. Multimetallic Nanoparticles as Alternative Antimicrobial Agents: Challenges and Perspectives. Molecules 2021, 26, 912. [Google Scholar] [CrossRef] [PubMed]
- Hejazy, M.; Koohi, M.K.; Bassiri Mohamad Pour, A.; Najafi, D. Toxicity of manufactured copper nanoparticles—A review. Nanomed. Res. J. 2018, 3, 1–9. [Google Scholar] [CrossRef]

Disclaimer/Publisher’s Note: The statements, opinions and data contained in all publications are solely those of the individual author(s) and contributor(s) and not of MDPI and/or the editor(s). MDPI and/or the editor(s) disclaim responsibility for any injury to people or property resulting from any ideas, methods, instructions or products referred to in the content. |
© 2024 by the authors. Licensee MDPI, Basel, Switzerland. This article is an open access article distributed under the terms and conditions of the Creative Commons Attribution (CC BY) license (https://creativecommons.org/licenses/by/4.0/).
Share and Cite
Rasheed, R.; Bhat, A.; Singh, B.; Tian, F. Biogenic Synthesis of Selenium and Copper Oxide Nanoparticles and Inhibitory Effect against Multi-Drug Resistant Biofilm-Forming Bacterial Pathogens. Biomedicines 2024, 12, 994. https://doi.org/10.3390/biomedicines12050994
Rasheed R, Bhat A, Singh B, Tian F. Biogenic Synthesis of Selenium and Copper Oxide Nanoparticles and Inhibitory Effect against Multi-Drug Resistant Biofilm-Forming Bacterial Pathogens. Biomedicines. 2024; 12(5):994. https://doi.org/10.3390/biomedicines12050994
Chicago/Turabian StyleRasheed, Rida, Abhijnan Bhat, Baljit Singh, and Furong Tian. 2024. "Biogenic Synthesis of Selenium and Copper Oxide Nanoparticles and Inhibitory Effect against Multi-Drug Resistant Biofilm-Forming Bacterial Pathogens" Biomedicines 12, no. 5: 994. https://doi.org/10.3390/biomedicines12050994
APA StyleRasheed, R., Bhat, A., Singh, B., & Tian, F. (2024). Biogenic Synthesis of Selenium and Copper Oxide Nanoparticles and Inhibitory Effect against Multi-Drug Resistant Biofilm-Forming Bacterial Pathogens. Biomedicines, 12(5), 994. https://doi.org/10.3390/biomedicines12050994

